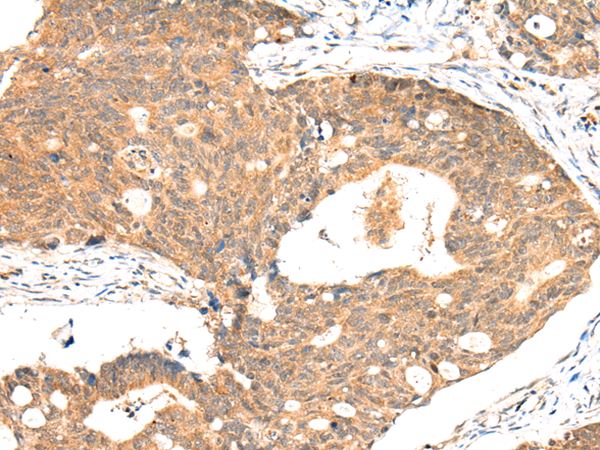

中文名稱:兔抗ACSL3多克隆抗體
|
Background: |
The protein encoded by this gene is an isozyme of the long-chain fatty-acid-coenzyme A ligase family. Although differing in substrate specificity, subcellular localization, and tissue distribution, all isozymes of this family convert free long-chain fatty acids into fatty acyl-CoA esters, and thereby play a key role in lipid biosynthesis and fatty acid degradation. This isozyme is highly expressed in brain, and preferentially utilizes myristate, arachidonate, and eicosapentaenoate as substrates. |
|
Applications: |
ELISA, WB, IHC |
|
Name of antibody: |
ACSL3 |
|
Immunogen: |
Synthetic peptide of human ACSL3 |
|
Full name: |
acyl-CoA synthetase long-chain family member 3 |
|
Synonyms: |
ACS3; FACL3; PRO2194 |
|
SwissProt: |
O95573 |
|
ELISA Recommended dilution: |
1000-2000 |
|
IHC positive control: |
Human cervical cancer and human gastric cancer |
|
IHC Recommend dilution: |
25-100 |
|
WB Predicted band size: |
80 kDa |
|
WB Positive control: |
231 cell |
|
WB Recommended dilution: |
200-1000 |

購物車
幫助
021-54845833/15800441009
